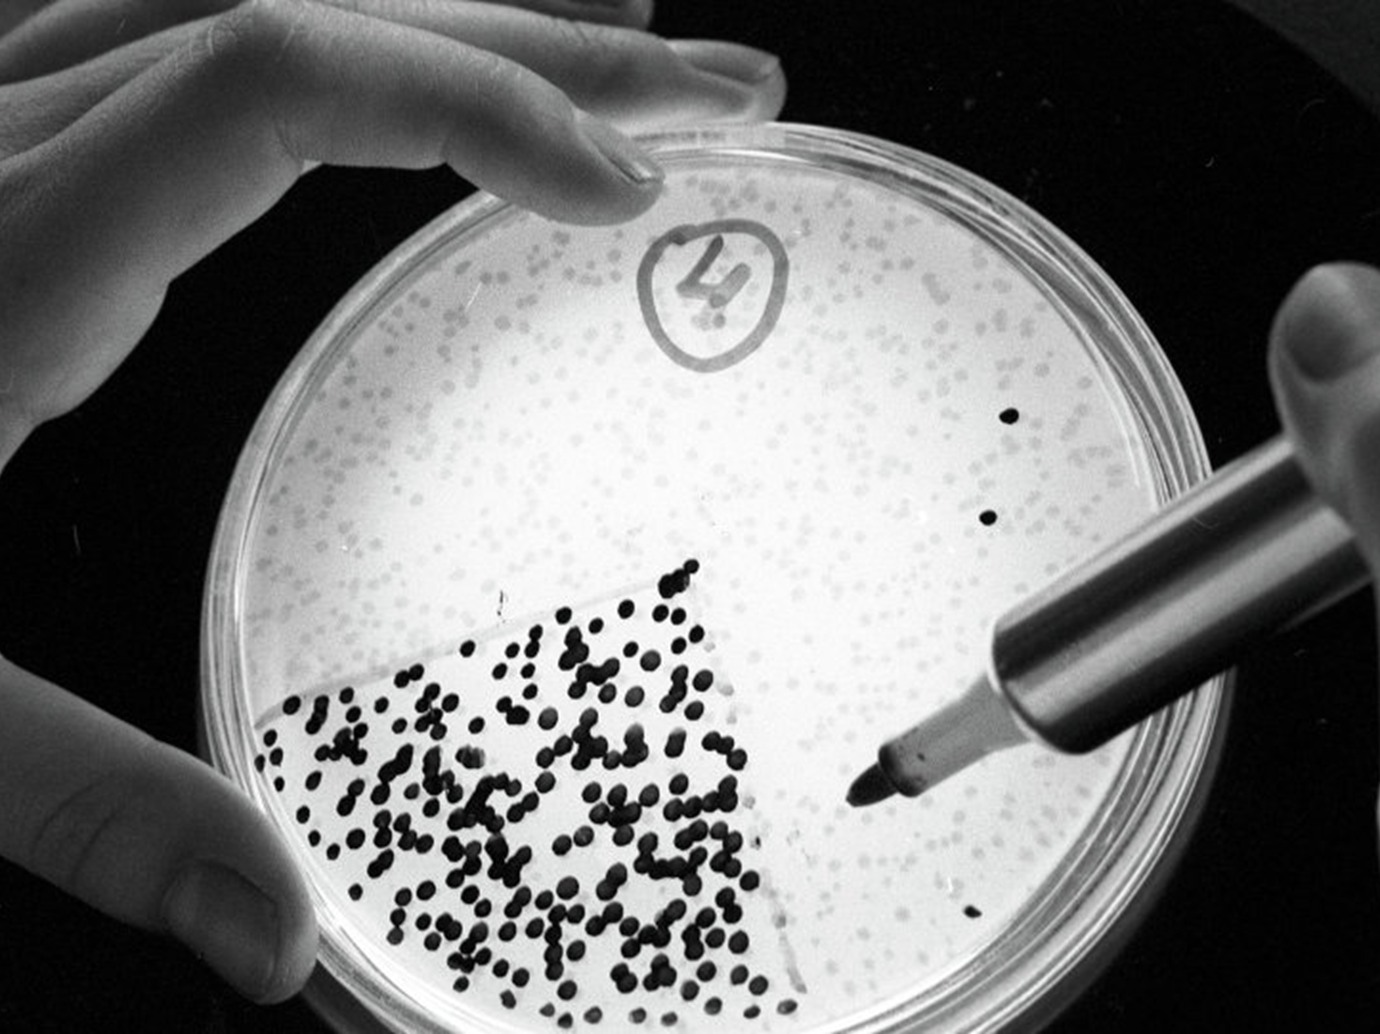

العثور على بكتيريا تعيد الشباب
منوعات
21 سبتمبر 2015 , 11:40ص
قنا
اقترب علماء البيولوجيا من التوصل إلى "أكسير الشباب" الذي يوفر للبشر حياة طويلة.
وصرح الطبيب الروسي فيكتور تشيرنيافسكي بأن علماء البيولوجيا أصبحوا قاب قوسين أو أدنى من التوصل إلى "أكسير الشباب الدائم"، موضحا أنه يتم تكوين هذا الأكسير من كائنات حية مجهرية تم العثور عليها في رفات حيوان الماموث المتجمد في إقليم ياقوتيا الروسي.
وتمكن الباحثون من ياقوتيا ومدينتين روسيتين أخريين هما يكاتيرينبورغ ونوفوسيبيرسك، من اكتشاف البكتيريا الحيوهوائية التي تستطيع العيش في بيئة باردة، في بقايا مخ الماموث.
وأظهرت دراسة أجراها الباحثون أن الكائنات الحية المجهرية المكتشفة التي يقدّر عمرها بـ20 ألفا إلى 40 ألف سنة، تزيد فئران التجارب حيوية، وتمكِّن حتى الفئران المتقدمة في السن من الإنجاب.
ويرى العلماء إمكانية تطبيق نفس التجربة على البشر لاسيما أن التجارب أظهرت أن البكتيريا القادرة على تجديد الشباب لا تستطيع العيش في البيئة الباردة فحسب، بل تحتفظ بالقدرة على إنتاج مواد بيولوجية منشطة.
والماموث هو نوع من الثدييات الفيلية من فصيلة الفيلة، وهو فيل ضخم منقرض كان يعيش في أوروبا الوسطى قبل مليون سنة.
ح.أ/م.ب